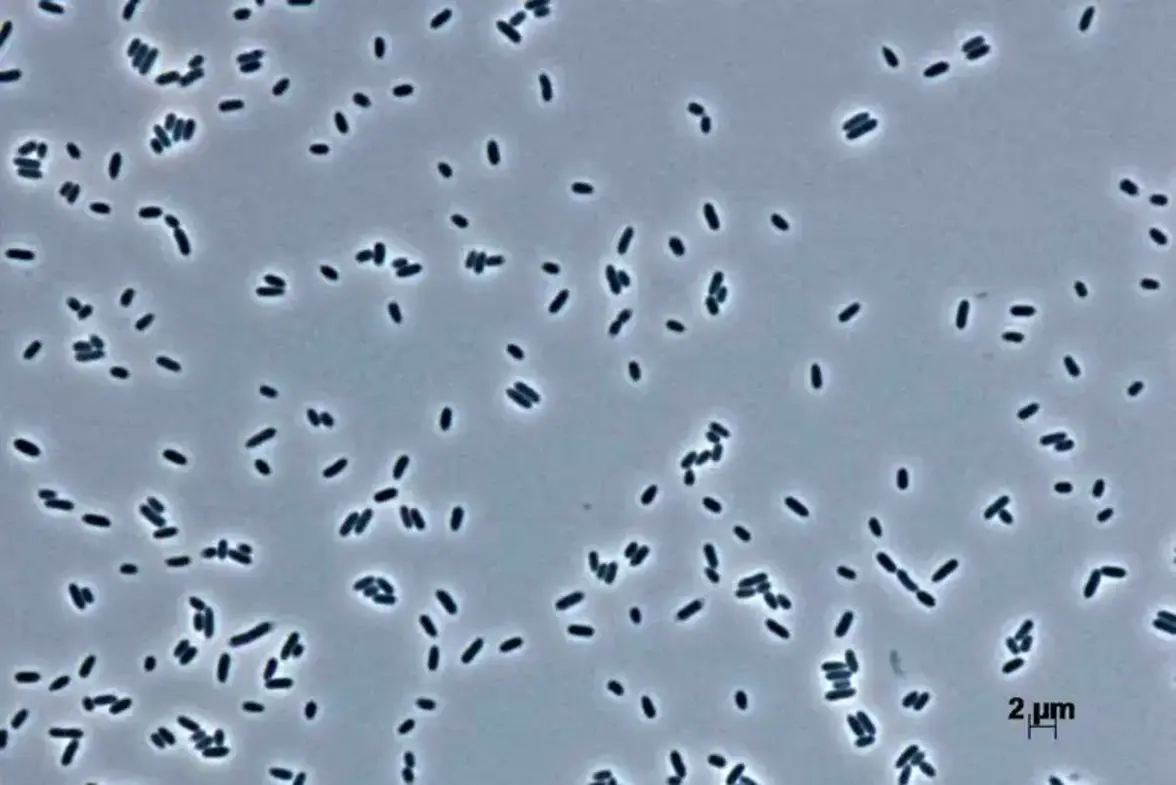
Подавляющий аппетит пробиотик помогает людям с избыточным весом сбросить вес

Экспериментальный пробиотик способствует снижению веса у людей с избыточным весом, соблюдающих диету с ограничением калорий.
Предыдущие исследования Пьера Дешлотта из Университетской больницы Руана во Франции и его коллег показывают, что пероральный прием кишечной бактерии Hafnia alvei помогает мышам с ожирением сбросить вес. Этот пробиотик вырабатывает молекулу ClpB, которая имитирует альфа-меланоцитстимулирующий гормон (α-МСГ), снижающий аппетит. Недавно исследователи обнаружили, что бактерия оказывает аналогичное действие и на людей с избыточным весом, представив свои результаты на конференции Targeting Microbiota 2022 в Париже на прошлой неделе.
Исследователи проконсультировали 212 человек с избыточным индексом массы тела (ИМТ) о том, как сократить потребление калорий на одну пятую часть в течение трех месяцев. Участников попросили поддерживать существующий уровень физической активности. В течение трех месяцев примерно половина участников также принимала таблетки, содержащие H. alvei, дважды в день. Остальные участники дважды в день принимали плацебо. Люди в обеих группах были одинакового возраста, роста и начального веса.
Среди тех, кто принимал пробиотик, 55% потеряли не менее 3% массы тела, по сравнению с 41% людей, принимавших плацебо. У людей с избыточным весом снижение массы тела на 3 % ассоциируется с уменьшением риска развития диабета 2 типа и сердечно-сосудистых заболеваний. В подтверждение этого авторы обнаружили, что у участников, принимавших пробиотик, уровень сахара в крови был значительно ниже, чем в группе плацебо, что снижает риск развития диабета 2 типа. Ни у одного из участников не было диабета 2 типа. Ежемесячные опросы также показали, что люди, принимавшие пробиотик, чувствовали себя значительно более сытыми в целом через два и три месяца после начала эксперимента, по сравнению с теми, кто принимал плацебо. Хотя неизвестно, как могло отличаться потребление пищи между двумя группами, люди, принимавшие пробиотик, могли потерять больше веса, если H. alvei вызывал у них чувство сытости, что позволяло им есть меньше. Исследователи также не исключают, что эти бактерии влияют на процесс расщепления жиров.
"Очень интересно обнаружить, что с помощью определенных штаммов бактерий можно таким образом регулировать вес тела", - говорит Адель Ракотонирина из Женевского университета (Швейцария). "Это может очень помочь, если вы хотите создать терапию против ожирения". Однако пробиотики действуют на людей по-разному в зависимости от их генетики, микробиома кишечника и общего метаболизма, отмечает она. В конечном итоге требуется индивидуальный подход к назначению пробиотиков, чтобы свести к минимуму любые побочные эффекты.